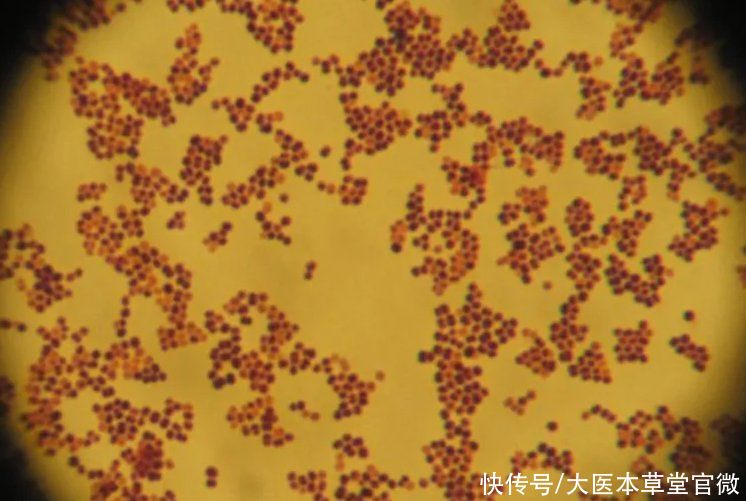
成分|反复口腔溃疡，这2种细菌不注意，用多少药都没用

你是否还因为反复性口腔溃疡而茶饭不思,被折磨得痛不欲生?都觉得口腔溃疡是个小问题,没想到它也有这么大的杀伤力,接下来我们就好好聊聊怎么预防这个‘磨人的小妖精’。
【1】选对牙膏经常反复口腔溃疡的易感人群 还不知道含有什么成分的牙膏不能用的,来看这里。
中国卫生产业期刊中《口腔溃疡的预防及治疗》于秀荣主编一文‘口腔溃疡的诱因’中有这样一句话:“牙膏中的十二烷基硫酸钠可能刺激口腔粘膜引发口腔溃疡。”
文章插图
十二烷基硫酸钠又名月桂醇硫酸酯钠,口腔溃疡易感人群回家可以都看看自己在用的牙膏中是不是都含有这种成分,如果口腔溃疡好了以后,排除饮食问题,用上这种牙膏又犯了,可能就是因为这种牙膏里月桂醇硫酸酯钠成分导致的。
文章插图
文章插图
如果您也出现了以上问题,可以尝试使用有机纯植物牙膏,不含类似于月桂醇硫酸酯钠、月桂醇聚醚硫酸酯钠等这种强刺激、微毒性的表面活性剂。
可以尝试碧蒙萱药鼠尾草碱性牙膏(PS:国内有机天然牙膏比较难找,暂时只找到了这一款,仅作为推荐,如果有更温和的牙膏大家也可以尝试的)。这款牙膏成分表非常喜人,全部都是植物成分和天然矿物成分,采用了非常温和的椰油基葡糖苷表活剂,具有去污强、温和、天然、绿色、无刺激的特点,对口腔溃疡易感人群非常友好;同时里面含有的药鼠尾草成分可有效清除、抑制血链球菌,帮助缓解预防口腔溃疡复发。
牙膏成分对过之后还要注意一下两种极易诱发口腔溃疡的细菌,有针对性之后才好在日常生活中通过药食或者其他手段针对性的防治。
【2】注意这两种细菌根据中国卫生产业期刊中《口腔溃疡的预防及治疗》一文以及下面全科口腔医学电子杂志中《复发性口腔溃疡的病因学研究进展》等众多研究报告中指出:幽门螺杆菌和溶血性链球菌对口腔溃疡都具有一定的作用(上面那个找的牙膏好像能抑制其中溶血性链球菌>.
文章插图
【2-1】幽门螺杆菌
这个幽门螺杆菌从1983年发现一直到现在都是让许多胃病患者非常头痛的一件事。幽门螺杆菌病的不良预后是胃癌。
文章插图
当然由于这种细菌对生存环境要求非常严苛,医学家们认为,彻底消灭幽门螺杆菌并非难事,90%的细菌感染者经过1~2周治疗后,体内的幽门螺杆菌往往能被消灭殆尽。
建议口轻溃疡容易复发的并且患有有慢性胃炎、胃溃疡和消化道溃疡人群可以去医院,进行幽门螺杆菌的检查,采用专业的杀菌治疗消灭幽门螺杆菌。同时在平时生活中要格外注意饮食健康,防止病从口入。
例如,少食多餐、细嚼慢咽,避免食用过于刺激的食物,饮食不过饱等对人都是有利的,尤其是对于消化性溃疡患者来说。蛋白质和维生素C是促进溃疡愈合的因素,但蛋白质的部分水解产物又是胃泌素的强刺激剂,以每日少量摄入为宜。饮食中维生素要丰富,少吃或不吃煎、炸、烟熏、盐腌等食品。
【2-2】溶血性链球菌
溶血性链球菌不像幽门螺杆菌一样主要寄植在胃部。溶血链球菌广泛存在于水、空气、尘埃、粪便及健康人和动物的口腔、鼻腔、咽喉中,可通过直接接触、空气飞沫或皮肤、黏膜伤口感染传播。
文章插图
所以面对这种细菌,平时更要做好口腔清洁,选购商品时要瞄准正规超市、渠道,防止食用因工厂生产过程、包装过程中产生纰漏从而导致污染的商品。
如果平时您没有胃部疾病但是依旧患有口腔溃疡,那么可能是因为牙膏成分选择不合适(含有月桂醇硫酸钠)或者是您口腔中本身存在溶血性链球菌,可以尝试以下草本方法缓解口腔溃疡,或者选用含有可以抑制溶血性链球菌的牙膏。
【1】蒲公英内服外敷。蒲公英能有效杀灭溶血性链球菌,从而抑制了致病的链球菌引起的变态反应,加快复发性口腔溃疡的愈合速度,并减轻溃疡病程中的疼痛。
治疗时咀嚼干蒲公英5-10克,一部分内服,一部分留于齿颊,起到内服与外敷双重功效。
注意:不可服食过量;对蒲公英过敏的人禁用;蒲公英性寒,胃寒者不用,喝冷饮禁用。
- 烟台市口腔医院|口腔反复溃烂?千万别大意,可能是口腔黏膜病在作祟
- 信用|看病无需反复排队交费!珠海这家医院推出信用就医服务
- 疾病|女性反复腰痛,除了腰部疾病,也可能是这3种疾病导致的,需了解
- 李女士|可能与HPV感染有关!东莞一女士出现反复瘙痒竟是得了外阴癌
- 圆孔|反复头晕头痛竟是心脏上的“小洞”在作怪
- 健康课|【大咖健康课】反复头晕头痛,竟是心脏上的“小洞”在作怪
- 治疗|老烟民肺癌手术后反复 肿瘤专家将向大家科普治疗相关知识
- 白斑|口腔反复有5个异常表现,需要提高警惕,或是疾病的表现
- 止痛|做对5件事,口腔溃疡好得快!
- 瘙痒|皮肤瘙痒要内外兼治,持续或反复发作可能是疾病预兆
